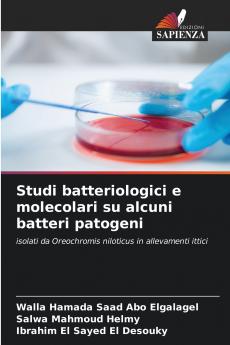
Studi batteriologici e molecolari su alcuni batteri patogeni

Paperback
₹4335
₹5481
20.91% OFF
(All inclusive*)
Delivery Options
Please enter pincode to check delivery time.
*COD & Shipping Charges may apply on certain items.
Review final details at checkout.
Looking to place a bulk order? SUBMIT DETAILS
Delivery Options
Please enter pincode to check delivery time.
*COD & Shipping Charges may apply on certain items.
Review final details at checkout.
About The Book
Description
Author(s)
Le malattie batteriche sono tra le cause più importanti di perdita di pesce. La piena comprensione dell'agente eziologico della patogenesi della biochimica dell'antigenicità e dell'interrelazione con i fattori ambientali e di stress è essenziale per una gestione e un controllo efficaci. D'altra parte la tilapia del Nilo (Orechromis niloticus) è considerata il pesce d'acqua dolce più coltivato al mondo. Ha contribuito all'acquacoltura mondiale fin dai tempi dell'antico Egitto e rimane una delle principali specie di pesci d'acqua dolce da coltivare.
Details
ISBN 13
9786208365547
Publication Date
-10-12-2024
Pages
-72
Weight
-111 grams
Dimensions
-152x229x4.38 mm